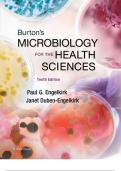
Test Bank For Burton's Microbiology for the Health Sciences&comma; Enhanced Edition 11th Edition By Paul G&period; Engelkirk&semi; Janet Duben-Engelkirk&semi; Robert C&period; Fader 9781284209952 Chapter 1-21 Complete Guide &period; 2

All 4 results
Sort by
Best selling Burton\'s Microbiology for the Health Sciences, Enhanced Edition notes

-
Test Bank For Burton's Microbiology for the Health Sciences, Enhanced Edition 11th Edition By Paul G. Engelkirk; Janet Duben-Engelkirk; Robert C. Fader 9781284209952 Chapter 1-21 Complete Guide . 2
- Exam (elaborations) • 883 pages • 2024 Popular
-
- $17.99
- 2x sold
- + learn more
Test Bank For Burton's Microbiology for the Health Sciences, Enhanced Edition 11th Edition By Paul G. Engelkirk; Janet Duben-Engelkirk; Robert C. Fader 9781284209952 Chapter 1-21 Complete Guide . 2

-
Portage Learning BIOD 171 Microbiology Lecture Exam Key 1-6. 2023
- Exam (elaborations) • 28 pages • 2023 Popular
- Available in package deal
-
- $15.99
- + learn more
Portage Learning BIOD 171 Microbiology Lecture Exam Key 1-6. 2023Portage Learning BIOD 171 Microbiology Lecture Exam Key 1-6. 2023Portage Learning BIOD 171 Microbiology Lecture Exam Key 1-6. 2023Portage Learning BIOD 171 Microbiology Lecture Exam Key 1-6. 2023Portage Learning BIOD 171 Microbiology Lecture Exam Key 1-6. 2023Portage Learning BIOD 171 Microbiology Lecture Exam Key 1-6. 2023Portage Learning BIOD 171 Microbiology Lecture Exam Key 1-6. 2023Portage Learning BIOD 171 Microbiology Lectur...
Newest Burton\'s Microbiology for the Health Sciences, Enhanced Edition summaries
-
Test Bank For Burton's Microbiology for the Health Sciences, Enhanced Edition 11th Edition By Paul G. Engelkirk; Janet Duben-Engelkirk; Robert C. Fader 9781284209952 Chapter 1-21 Complete Guide . 2
- Exam (elaborations) • 883 pages • 2024 New
-
- $17.99
- 2x sold
- + learn more
Test Bank For Burton's Microbiology for the Health Sciences, Enhanced Edition 11th Edition By Paul G. Engelkirk; Janet Duben-Engelkirk; Robert C. Fader 9781284209952 Chapter 1-21 Complete Guide . 2

-
Portage Learning BIOD 171 Microbiology Lecture Exam Key 1-6. 2023
- Exam (elaborations) • 28 pages • 2023 New
- Available in package deal
-
- $15.99
- + learn more
Portage Learning BIOD 171 Microbiology Lecture Exam Key 1-6. 2023Portage Learning BIOD 171 Microbiology Lecture Exam Key 1-6. 2023Portage Learning BIOD 171 Microbiology Lecture Exam Key 1-6. 2023Portage Learning BIOD 171 Microbiology Lecture Exam Key 1-6. 2023Portage Learning BIOD 171 Microbiology Lecture Exam Key 1-6. 2023Portage Learning BIOD 171 Microbiology Lecture Exam Key 1-6. 2023Portage Learning BIOD 171 Microbiology Lecture Exam Key 1-6. 2023Portage Learning BIOD 171 Microbiology Lectur...

-
Portage Learning BIOD 171 Microbiology Lecture Exam Key 1-6 ALL ANSWERS 100% CORRECT SOLUTION AID GRADE A+ Course Portage Learning BIOD 171 Microbiology Lecture Exam Key 1-6. (BIOD171) Institution Portage Learning True or False: A virus is considered a mi
- Package deal • 10 items • 2025 New
-
- $62.45
- + learn more
Portage Learning BIOD 171 Microbiology Lecture Exam Key 1-6 ALL ANSWERS 100% CORRECT SOLUTION AID GRADE A+ Course Portage Learning BIOD 171 Microbiology Lecture Exam Key 1-6. (BIOD171) Institution Portage Learning True or False: A virus is considered a mi
Do you also write (revision) notes yourself? Put them up for sale and earn every time your document is purchased.

-
PORTAGE LEARNING TEST BANKS FINAL EXAM QUESTIONS _ ANSWERS 1000 CORRECT LATEST UPDATE 2024 |VERIFIED 100% COMPLETE
- Package deal • 19 items • 2024 New
-
- $100.49
- + learn more
PORTAGE LEARNING TEST BANKS FINAL EXAM QUESTIONS _ ANSWERS 1000 CORRECT LATEST UPDATE 2024 |VERIFIED 100% COMPLETEPORTAGE LEARNING TEST BANKS FINAL EXAM QUESTIONS _ ANSWERS 1000 CORRECT LATEST UPDATE 2024 |VERIFIED 100% COMPLETEPORTAGE LEARNING TEST BANKS FINAL EXAM QUESTIONS _ ANSWERS 1000 CORRECT LATEST UPDATE 2024 |VERIFIED 100% COMPLETEPORTAGE

How did he do that? By selling his revision notes on Stuvia. Try it yourself! Discover all about earning on Stuvia
